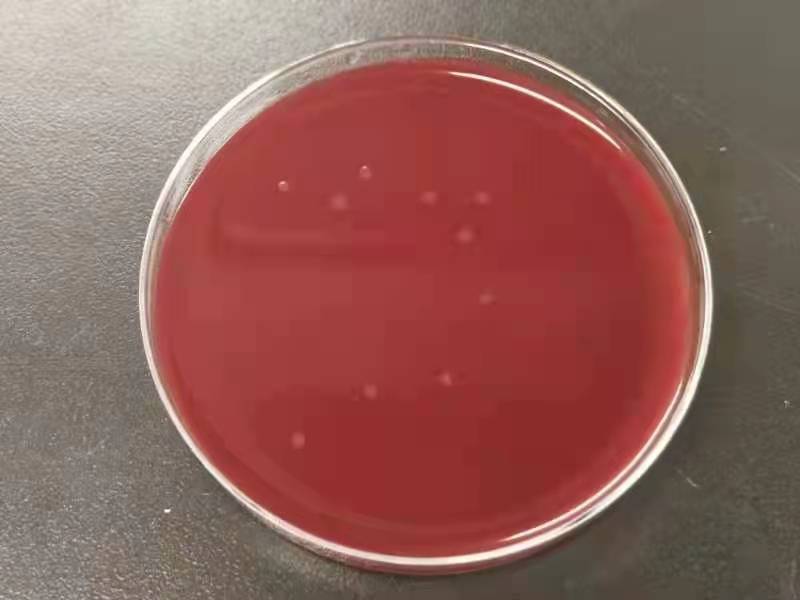

大肠杆菌载体 E.coli Vector 大肠杆菌宿主菌株 E.coli 细菌广宿主载体 bacateria broad range host vector 链霉菌载体及菌株 Streptomyces 芽孢杆菌载体 Bacillus vector 芽孢杆菌宿主菌株 乳酸菌载体 lactic acid bacteria vector 乳酸菌宿主菌株 lactic acid bacteria strain 细菌基因敲除载体 毕赤酵母载体 毕赤酵母宿主菌株 酿酒酵母载体 酿酒酵母宿主菌株 丝状真菌载体 mold/fungi vector 乳酸克鲁维酵母载体 酵母真菌基因敲除基因编辑载体 植物细胞载体 plant cell vector 农杆菌菌株Agrobacterium tumefaciens strain 植物细胞基因敲除载体 plant cell 哺乳动物细胞载体 哺乳动物细胞荧光载体 荧光素酶报告基因载体 哺乳动物细胞基因敲除基因编辑载体 杂交系统 慢病毒载体 腺病毒载体 逆转录病毒载体 杆状病毒表达载体 基因干扰 RNAi载体 基因/cDNA/ORF 转座子质粒系统 transposon 金黄色葡萄球菌载体 staphylococcus aureus 假单胞菌载体 噬菌体 phage 不动杆菌载体 双岐杆菌载体 藻类表达载体 链球菌载体 厌氧菌载体 基因治疗载体 大肠杆菌基因突变体菌株 细菌荧光质粒 白色念珠菌载体 体外转录载体 谷氨酸棒杆菌载体 酿酒酵母基因突变体菌株 线虫载体 斑马鱼载体 Zebra fish 果蝇,昆虫载体Drosophila 鱼类细胞载体 fish cell 分支杆菌载体 克雷伯菌 枯草芽孢杆菌基因缺失突变株 基因ORF 金黄色葡萄球菌基因敲除突变株 肺炎克雷伯菌基因敲除突变株
| 产品编号 | 产品名称 |
| 幽门螺旋杆菌ATCC26695,毒力强,携带毒力基因 cagA |
H. pylori wild strain containing cagA, vacA, and ureB
基因组序列:NCBI Genbank (NC_000915.1)